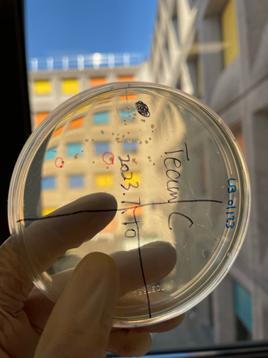

中法生物科学中外合作办学班2021级
2023年巴黎萨克雷大学研学夏令营日志-07.12
记录小组:"组队去巴黎市中心组"
组长:高旸
组员:夏锦添/邓锴标/骆德莉/戴佩延/朱鹭云
早上,我们继续研究在枫丹白露森林池塘中收集的水样品中的微生物的实验。团队中的每个人都有不同的任务,例如在不同的选择性培养基上分离细菌,并将其培养在试管中以研究其呼吸类型、代谢类型等等。我们进行了一些生物信息学的训练。我们学习了如何处理核苷酸序列。为了做到这一点,首先我们使用程序检查数据的冗余性,这表明物种的丰度,然后我们识别并去除冗余数据,以确保数据的准确。最有趣的部分是使用Silva绘制我们分析的序列中不同分类阶元的图表,这对我们之后的分析非常有帮助。
下午iGEM的成员参加了和Saclay队伍对第一次会议,并且汇报了近期的项目进展和收集到的资料,同时,我们还与法国的iGEM团队负责人Doriane BLAISE进行了交流讨论,对大赛的各项内容有了全面的认识。

晚餐是Breton buffet(法国的一种特色菜系),包括海鲜、枫糖浆等在内的菜品。所有的海鲜都是腌制过的,包括三文鱼、虾以及鱼肉等,给我们带来了丰富的味觉体验。里面还有一种主食,面饼里面夹着三明治与火腿,吃完十分的满足。最后便是丰富的点心,搭配上枫糖浆,十分美味。
In the morning, we continued to do our experiments studying the microorganisms in the water samples we collected in the Fontainebleau forest ponds. Each person in a team had different tasks to do, such as isolating bacteria on different selective media and culturing them in tubes to study their respiratory types, metabolism types and so on. We also did some trainings of bioinformatics. We learned how to process the nucleotide sequences. To do this, first we used programs to check the redundancy of the data, which indicates the abundance of the species. And then we Identified and removed the chimeras to make sure the data was clean. Then the most interesting part is to use Silva to make a plot of the different taxonomy in the sequence we analyzed. It’s a nice training and and what we have learned would be very helpful for our analysis later.
In the afternoon, iGEM members participated in the first meeting of the team of Saclay, and reported the recent project progress and collected data. At the same time, we also communicated and discussed with Dorian BLAISE, the team leader of iGEM in France, and had a comprehensive understanding of the contents of the competition.
Today's dinner is Breton buffer (a French specialty dish), which includes seafood, maple syrup, and other dishes. All seafood is marinated, including salmon, shrimp, and fish meat, providing us with a rich taste experience. There is also a staple food inside, with sandwiches and ham inside the pastry, which is very satisfying after eating. Finally, there are rich snack, which are delicious with maple syrup.